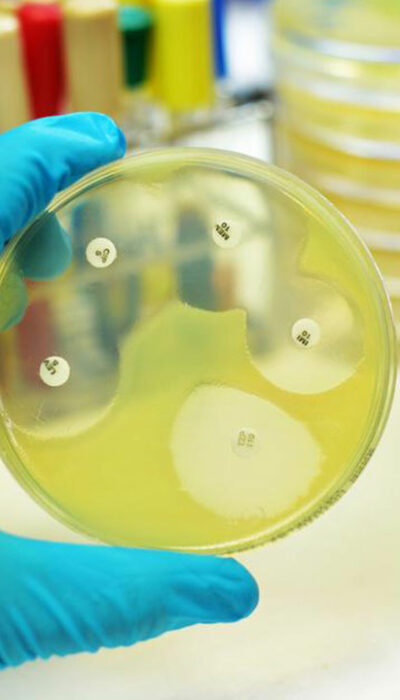

Do You Have Any of These Bladder Cancer Symptoms?
Keeping an eye out for these common bladder cancer symptoms can be effective in early diagnosis and treatment of the disease. The bladder in your body is a balloon-shaped organ that stores urine, and it is located in your pelvic region. When cancer cells start to develop inside this organ, the condition is termed as bladder cancer. Since the bladder holds urine until it is passed out of your body, it plays an important role as part of the urinary tract. Hence, developing bladder cancer can have a serious effect on the function of your body (particularly the kidneys and bowel), and if left untreated, it can spread fast to other parts of your body. This disease affects both men and women, although men are more likely to develop it. Also, old age increases your chances of developing bladder cancer as it is more commonly diagnosed in people over the age of 65. Bladder cancer usually starts developing when healthy cells in the lining of your bladder change and starts to multiply at a rapid pace. This forms a mass called a tumor, which can either be benign or malignant. A benign tumor is one that can grow in size, but will not spread to other areas, whereas a malignant tumor refers to a cancerous growth that can affect other parts of your body. The types of bladder cancer are broadly categorized depending on the extent to which the disease has invaded your bladder wall. The two types of bladder cancer are– Non-invasive : This type of the disease is basically a cancer that is still contained in the inner layer of cells in the bladder (the transitional epithelium), and has not progressed into the deeper layers. This type is easier to treat. Invasive : This type of bladder cancer means one that has the potential to spread to other parts of your body, including the lymph nodes, liver, and the lungs.